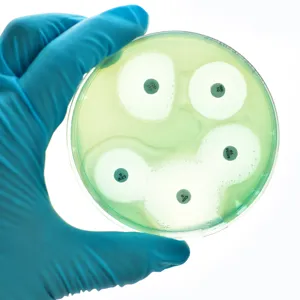
En hanskekledt hånd som holder en bakterieskål

Definisjonene for klassifisering av bakteriers følsomhet for antibiotika ble endret i 2019. De nye kategoriene er:
- Følsom ved standarddose (S): Høy sannsynlighet for terapeutisk suksess ved bruk av standard doseregime.
- Følsom ved økt eksponering (I): Høy sannsynlighet for terapeutisk suksess hvis doseringen tilpasses eller middelet oppkonsentreres i infeksjonsfokus.
- Resistent (R): Høy sannsynlighet for terapisvikt, selv ved økt eksponering.
Man kan oppnå økt eksponering på flere måter:
- Økt dosering (økte enkeltdoser / hyppigere dosering / forlenget infusjonstid).
- Overgang fra peroral til intravenøs administrering.
- Ved å utnytte middelets egenskaper; ved behandling av urinveisinfeksjoner velge et middel som skilles ut gjennom nyrene og har høy konsentrasjon i urin.
Nyttige lenker
Definisjonene er utviklet av EUCAST, European Committee on Antimicrobial Susceptibility Testing, og tilrettelagt for norske forhold ved AFA, Arbeidsgruppen for antibiotikaspørsmål og metoder for resistensbestemmelse.
Sist oppdatert 10.01.2025